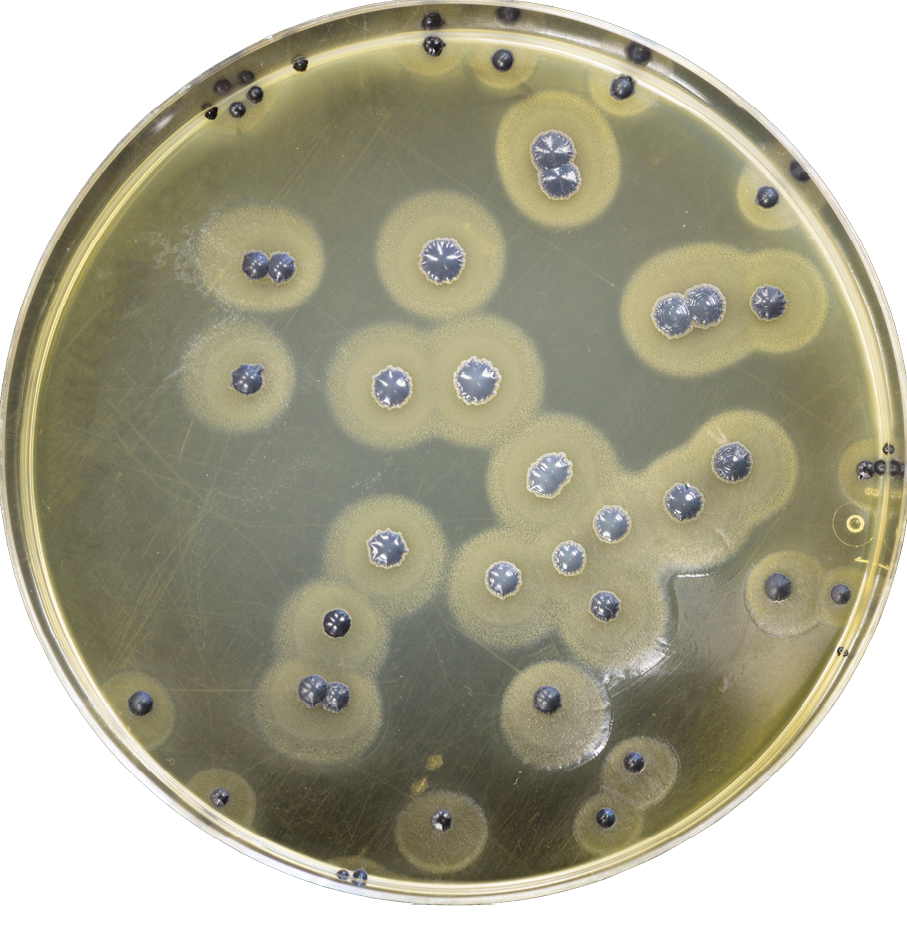
Colonias bacterianas formando un biofilm en una placa de Petri

format_list_bulleted Contenido
- Introducción: Los arquitectos invisibles del mundo microscópico
- Los plásmidos: más que simples pasajeros genéticos
- El biofilm: el hormigón armado de la microbiología
- El mecanismo molecular de la construcción
- Análisis visual
- Implicaciones clínicas y farmacéuticas
- Buscando soluciones: ¿atacar al arquitecto o al edificio?
- El futuro de la resistencia bacteriana
- Conclusión: Una carrera armamentista a escala microscópica
En la guerra milenaria entre los microorganismos y la medicina, siempre hemos imaginado a las bacterias como entidades individuales que mutan para sobrevivir. Sin embargo, la realidad es mucho más colectiva y estratégica. Un reciente estudio publicado en la revista Current Biology ha revelado que las bacterias cuentan con "consejeros externos" extremadamente eficaces: los plásmidos. Estos fragmentos de ADN circular, que se mueven entre bacterias como si fueran polizones en un barco, no se limitan a dar instrucciones genéticas; ahora sabemos que son capaces de orquestar la construcción de auténticos escudos físicos que dejan a los antibióticos fuera de combate.
science Ingeniería civil a escala microscópica
El hallazgo, liderado por investigadores de la Universidad de Oxford y el Imperial College de Londres, cambia fundamentalmente nuestra comprensión de la resistencia bacteriana. Ya no hablamos solo de que una bacteria aprenda a "escupir" el fármaco o a desactivarlo químicamente; hablamos de ingeniería civil a escala microscópica, donde los plásmidos actúan como arquitectos que diseñan y construyen estructuras defensivas con una precisión aterradora.
Como microbiólogo, me resulta fascinante cómo este descubrimiento revela un nivel de sofisticación en el mundo bacteriano que desafía nuestra percepción de los microorganismos como seres simples. Las bacterias, guiadas por estos "polizones" genéticos, se han convertido en ingenieras capaces de construir fortalezas biológicas que nuestra medicina actual apenas puede comenzar a comprender, y mucho menos combatir eficazmente.
dna Los plásmidos: más que simples pasajeros genéticos
Para entender este fenómeno, debemos primero visualizar qué es un plásmido. Imaginemos que la bacteria tiene su libro de instrucciones principal (su cromosoma). Un plásmido es como un pequeño folleto adicional, un "anexo" de ADN que existe fuera del cromosoma principal y que puede replicarse de manera autónoma. Lo que lo hace verdaderamente especial es su capacidad para moverse entre bacterias a través de un proceso llamado conjugación.


Hasta ahora, sabíamos que estos plásmidos portaban los genes de resistencia a los antibióticos. Pero lo que este estudio revela es mucho más ambicioso: ciertos plásmidos de la familia IncP-1 no solo promueven la formación de biofilm, sino que lo convierten en un material con una "superfuerza" estructural. Estos plásmidos han evolucionado para ser mucho más que simples portadores de genes; se han convertido en directores de orquesta biológica.
architecture La evolución de los plásmidos como elementos genéticos móviles
Los plásmidos IncP-1 representan un ejemplo fascinante de evolución convergente. Han desarrollado una estructura modular altamente eficiente que les permite persistir en una amplia variedad de especies bacterianas. Su éxito evolutivo se basa en su capacidad para proporcionar beneficios inmediatos a sus huéspedes (como resistencia a antibióticos) a cambio de la oportunidad de replicarse y propagarse. Esta relación simbiótica ha llevado a la aparición de "superplásmidos" que pueden coordinar funciones complejas a nivel de comunidad bacteriana.
Lo más extraordinario es que estos plásmidos han desarrollado la capacidad de alterar el metabolismo de su huésped. En lugar de ser simples pasajeros genéticos, toman el control de las funciones celulares de la bacteria para asegurar su propia supervivencia y propagación. Este nivel de control es lo que les permite orquestar la construcción de biofilms con propiedades estructurales específicas que benefician tanto al plásmido como a su huésped bacteriano.
bubble_chart El biofilm: el hormigón armado de la microbiología
El biofilm es, en esencia, una especie de barro biológico, una matriz de azúcares y proteínas que pega a las bacterias entre sí y a las superficies. Sin embargo, el biofilm inducido por estos plásmidos "polizones" es algo completamente diferente. Los investigadores han descubierto que estos biofilms actúan como el hormigón armado de la microbiología.

Un biofilm normal es como un montón de arena: protege algo, pero es relativamente fácil de dispersar. El biofilm inducido por estos plásmidos, en cambio, tiene una densidad y una viscosidad que la medicina actual no había previsto. Al introducir instrucciones genéticas específicas, el plásmido altera la composición química de la matriz extracelular, aumentando su resistencia estructural hasta niveles que desafían los tratamientos convencionales.
Propiedades estructurales mejoradas
El biofilm inducido por plásmidos presenta varias características estructurales mejoradas:
- Densidad aumentada: La matriz es significativamente más compacta, dificultando la penetración de moléculas externas
- Viscosidad elevada: Mayor cohesión estructural que resiste fuerzas mecánicas
- Composición química alterada: Mayor proporción de polisacáridos específicos que proporcionan mayor resistencia
- Canales de comunicación intercelular: Redes más eficientes para la transferencia de señales y nutrientes
Este escudo físico cumple una doble función. Primero, actúa como una barrera mecánica: las moléculas de los antibióticos simplemente no pueden difundirse a través de esa red tan tupida. Segundo, facilita la propagación del plásmido: en una comunidad tan apretada, es mucho más fácil pasar el ADN polizón a las bacterias vecinas, creando un efecto dominó de protección y resistencia.
biotech El mecanismo molecular de la construcción
El proceso mediante el cual los plásmidos orquestan la construcción del biofilm es un ejemplo remarkable de coordinación biológica. Todo comienza cuando el plásmido se integra en una bacteria huésped y comienza a expresar genes específicos que alteran el metabolismo celular.
Estos genes codifican enzimas especializadas que modifican la producción de polisacáridos extracelulares. Las bacterias comienzan a secretar mayores cantidades de estos azúcares estructurales, que luego se polimerizan para formar la matriz del biofilm. Pero aquí está el truco: los plásmidos también controlan las enzimas degradativas que limitan el crecimiento del biofilm, asegurando que alcance una densidad óptima para la protección pero no tan alta que impida la difusión de nutrientes.
sync Regulación fina y control temporal
El sistema de regulación es extremadamente sofisticado. Los plásmidos pueden detectar condiciones ambientales y ajustar la producción de biofilm en consecuencia. En presencia de antibióticos, por ejemplo, aceleran la construcción del biofilm. Cuando las condiciones son favorables, pueden ralentizar el crecimiento para conservar energía. Esta capacidad de respuesta dinámica permite a las bacterias adaptarse rápidamente a los cambios en su entorno, maximizando sus posibilidades de supervivencia.
Además, los plásmidos coordinan la expresión génica diferencial en diferentes regiones del biofilm. Las bacterias en el núcleo del biofilm pueden expresar genes diferentes a las de la periferia, creando microambientes especializados que optimizan tanto la protección como la eficiencia metabólica. Este nivel de organización espacial es similar al de organismos multicelulares complejos, lo cual es extraordinario considerando que estamos hablando de comunidades bacterianas.
play_circle Análisis visual
Para comprender mejor la complejidad de estos mecanismos, te invitamos a ver este análisis que explora visualmente cómo los plásmidos se propagan entre bacterias y coordinan la formación de biofilms resistentes:
insights La conjugación bacteriana en acción
El video muestra el proceso de conjugación bacteriana, el mecanismo mediante el cual los plásmidos se transfieren de una bacteria a otra. Este proceso es fundamental para entender cómo la resistencia a los antibióticos se disemina rápidamente a través de poblaciones bacterianas. Lo que es particularmente notable es cómo este proceso se coordina con la formación del biofilm, creando un ciclo de retroalimentación positiva que acelera tanto la propagación de los plásmidos como la fortificación de la comunidad bacteriana.
warning Implicaciones clínicas y farmacéuticas
Las implicaciones de este descubrimiento son profundas y, en muchos casos, preocupantes. En entornos hospitalarios, las bacterias que portan estos plásmidos "arquitectos" pueden colonizar superficies quirúrgicas, catéteres y otros dispositivos médicos, creando reservorios que son virtualmente imposibles de esterilizar con métodos convencionales.
local_hospital Entornos hospitalarios
Los biofilms resistentes pueden colonizar superficies quirúrgicas y dispositivos médicos, creando reservorios persistentes que son extremadamente difíciles de eliminar.
Reducción en la eficacia de los desinfectantes convencionales contra biofilms maduros
medication Tratamientos antimicrobianos
Los biofilms actúan como barreras físicas que impiden que los antibióticos lleguen a su objetivo, reduciendo drásticamente la eficacia de los tratamientos estándar.
Aumento en la concentración mínima inhibitoria (MIC) necesaria para bacterias en biofilm
share Propagación de resistencia
La alta densidad bacteriana en los biofilms facilita la transferencia horizontal de plásmidos, acelerando la diseminación de genes de resistencia entre diferentes especies bacterianas.
Tasa de transferencia de plásmidos por hora en biofilms maduros
El problema se agrava porque estos biofilms no solo resisten a los fármacos, sino también a los procesos de limpieza mecánica y al propio sistema inmunitario. Dentro del biofilm, las bacterias están protegidas de la acción de los anticuerpos, del ataque de las células fagocíticas y de los tratamientos antimicrobianos. Esto crea un santuario donde las bacterias pueden persistir durante meses o incluso años, esperando oportunidades para diseminarse e infectar a nuevos huéspedes.
trending_up La paradoja del coste energético
Durante años, la microbiología sostuvo que portar plásmidos era un "lastre" para la bacteria, ya que replicar ese ADN extra consumía energía. Sin embargo, este estudio demuestra que el beneficio de construir el escudo compensa con creces el gasto energético. En un entorno hostil como un cuerpo humano lleno de antibióticos, la bacteria que gasta energía en construir el búnker es la única que sobrevive para contar la historia. Esta realización obliga a la industria farmacéutica a repensar completamente su enfoque para combatir las infecciones bacterianas.
Además, estos biofilms facilitan la transferencia horizontal de genes a un ritmo acelerado. En una comunidad tan apretada, los plásmidos pueden saltar fácilmente entre diferentes especies bacterianas, incluyendo potencialmente a patógenos más virulentos. Esto crea un caldo de cultivo perfecto para la aparición de superbacterias resistentes a múltiples fármacos, un escenario que los epidemiólogos consideran una de las mayores amenazas para la salud pública global del siglo XXI.
lightbulb Buscando soluciones: ¿atacar al arquitecto o al edificio?
Frente a este desafío monumental, la comunidad científica está explorando múltiples estrategias. La investigación abre una nueva vía: el desarrollo de terapias "anti-plásmido" o "anti-biofilm". Si logramos identificar las señales químicas que el polizón envía a la bacteria para que empiece a construir el escudo, podríamos bloquear esa comunicación.





